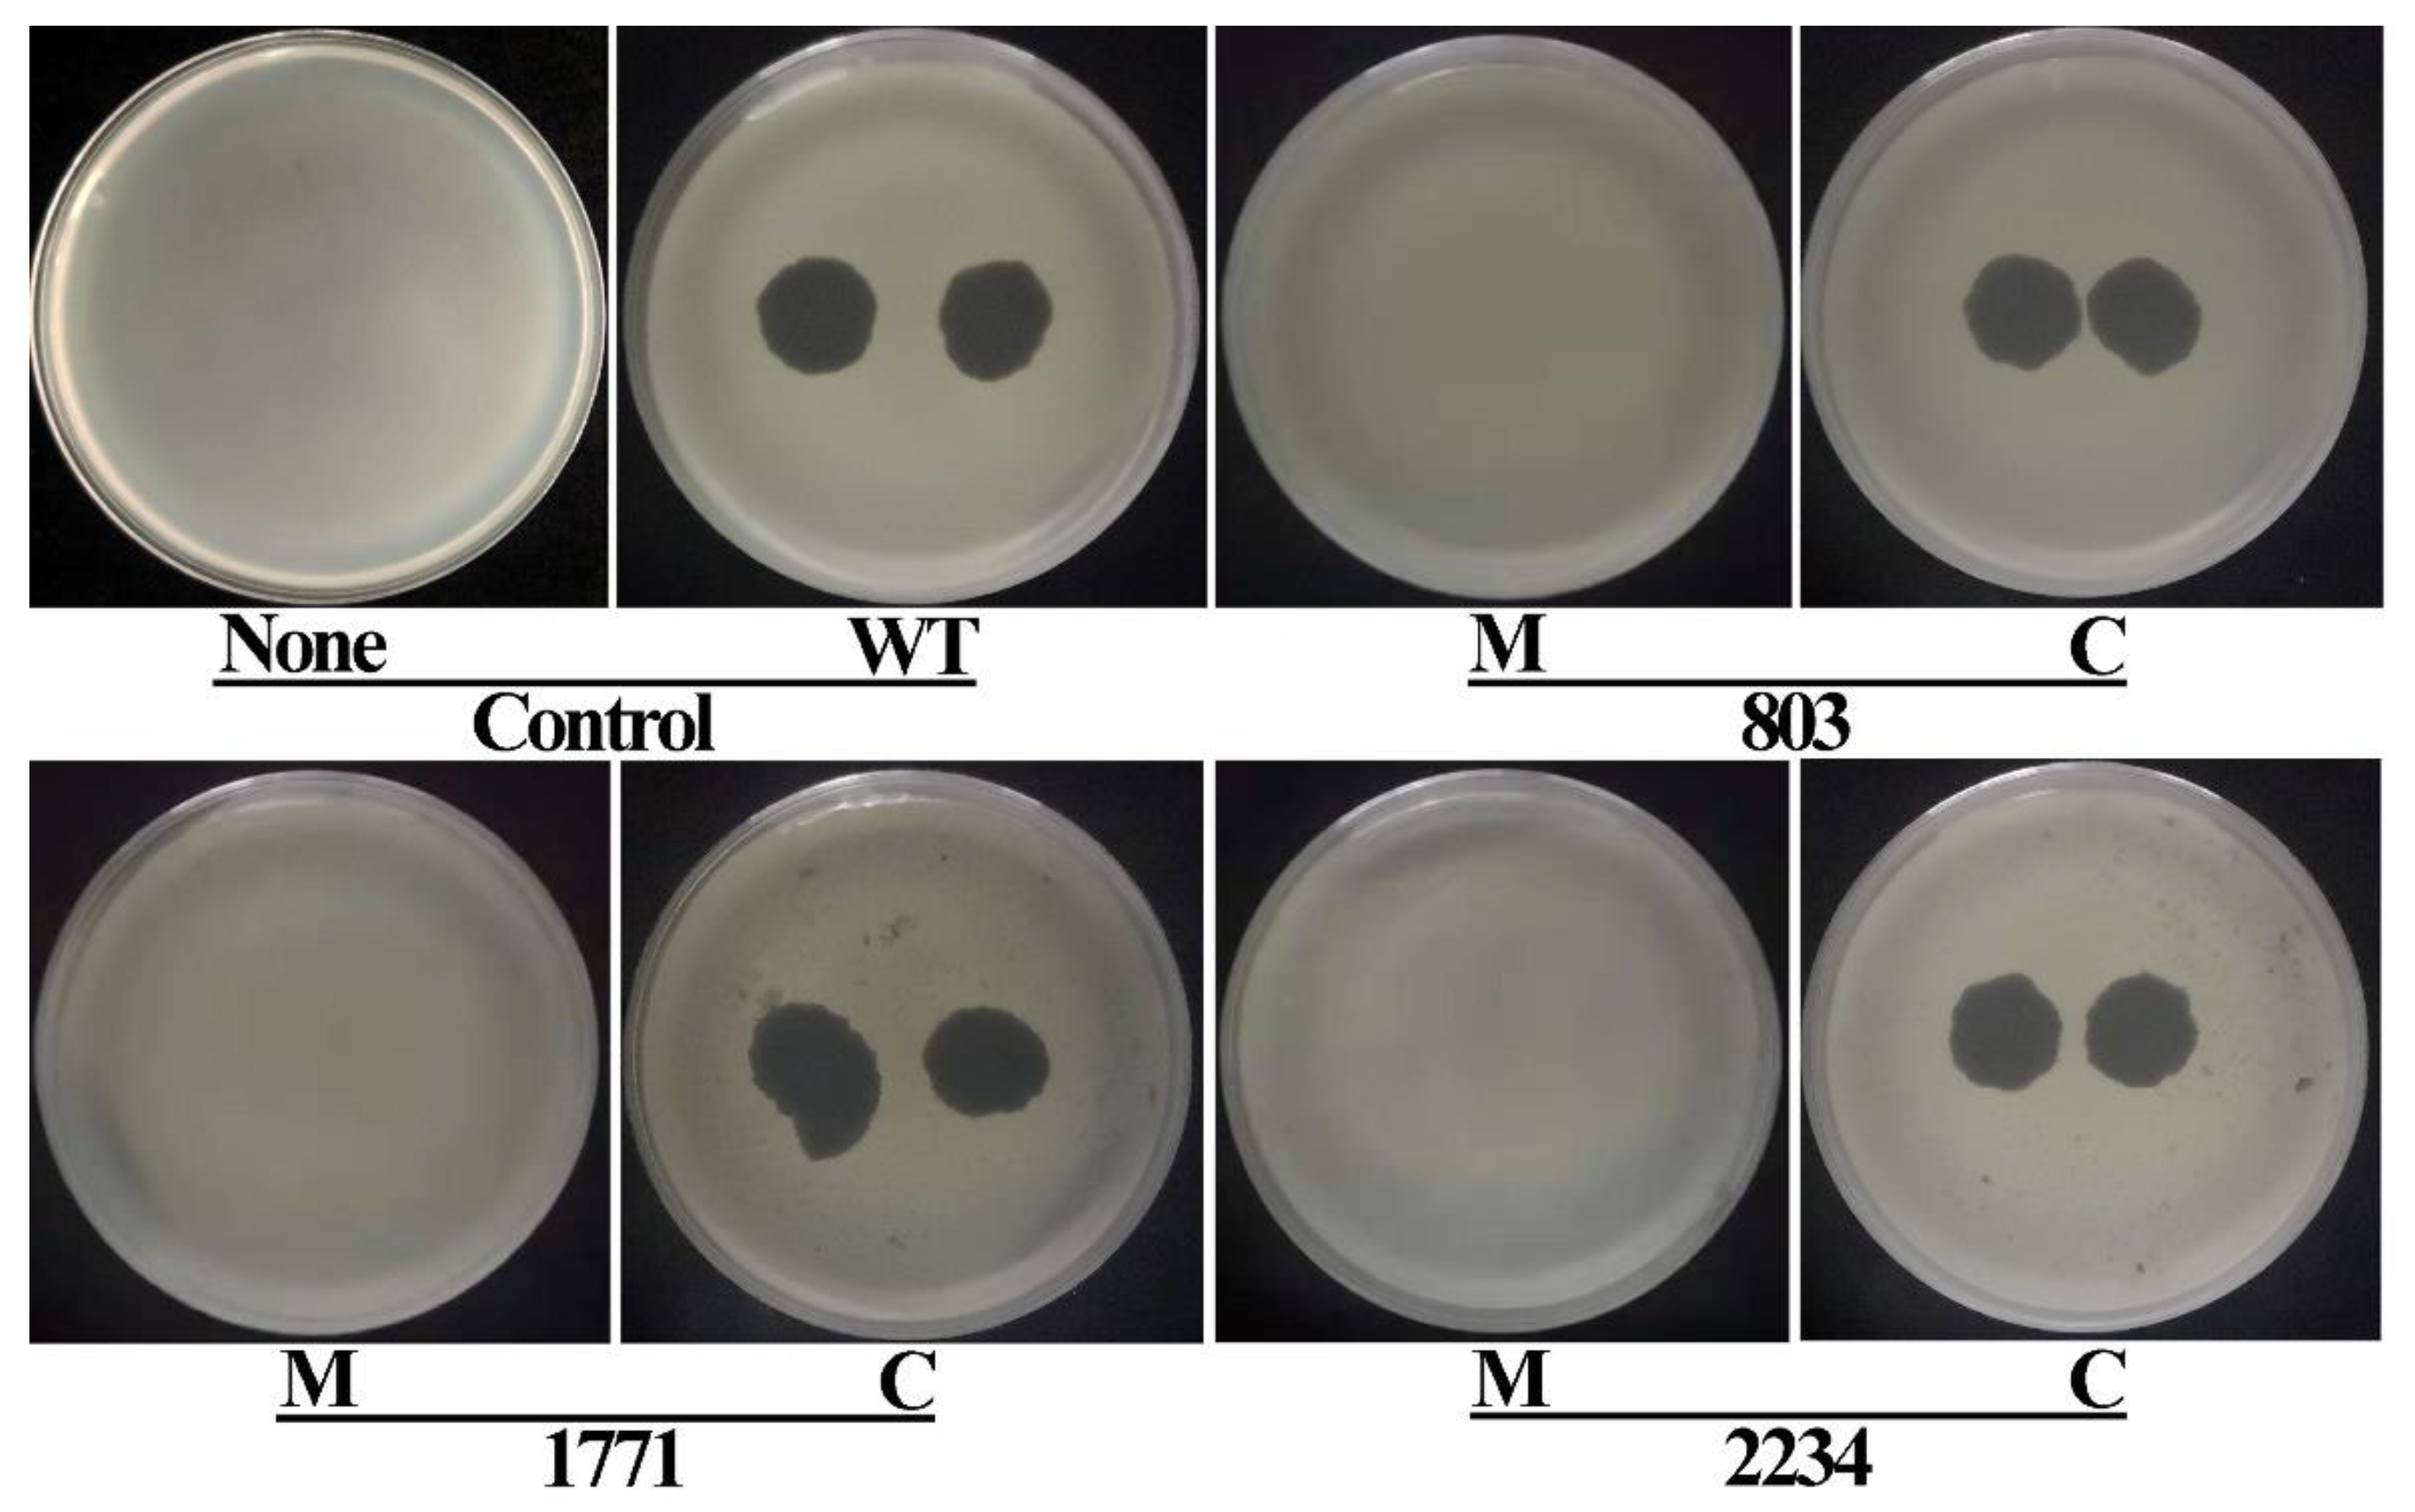
Viruses 14 01770 g004 Viruses 14 01770 g004

Phage Resistance Reduced the Pathogenicity of Xanthomonas oryzae pv. oryzae on Rice
Abstract
1. Introduction
2. Materials and Methods
2.1. Bacterial Strains and Growth Conditions
2.2. Bacteriophage and Plasmids
2.3. Phage Infection Assay
2.4. Construction of Tn5 Mutants Library
2.5. Identification of the Insertion Site of the Tn5 Mutants
2.6. Construction and Complementation of Knockout Mutants
2.7. Pathogenicity Assays in Rice Seedlings
2.8. Motility and Biofilm Formation Assay
2.9. Statistical Analysis
3. Results
3.1. Screening for Genes Responsible for Phage Resistance Using a Tn5 Mutant Library
3.2. Identification of Genes That Confer Phage Resistance
3.3. Functional Prediction of Phage-Resistance Mediating Genes
3.4. Verification of Phage Resistance by Knockout Mutation and Complementation
3.5. Pathogenicity Analysis of Tn5 Mutants
3.6. Verification of Pathogenicity Attenuation by Knockout Mutation and Complementation
3.7. Effects of Gene Knockout on Motility and Biofilm Formation
4. Discussion
5. Conclusions
Author Contributions
Funding
Institutional Review Board Statement
Informed Consent Statement
Data Availability Statement
Conflicts of Interest
References
- Ahmed, T.; Noman, M.; Jiang, H.; Shahid, M.; Ma, C.; Wu, Z.; Nazir, M.M.; Ali, M.A.; White, J.C.; Chen, J. Bioengineered chitosan-iron nanocomposite controls bacterial leaf blight disease by modulating plant defense response and nutritional status of rice (Oryza sativa L.). Nano Today. 2022, 45, 101547. [Google Scholar] [CrossRef]
- Ogunyemi, S.O.; Zhang, M.; Abdallah, Y.; Ahmed, T.; Qiu, W.; Ali, M.A.; Yan, C.; Yang, Y.; Chen, J.; Li, B. The bio-synthesis of three metal oxide nanoparticles (ZnO, MnO2, and MgO) and their antibacterial activity against the bacterial leaf blight pathogen. Front. Microbiol. 2020, 11, 588326. [Google Scholar] [CrossRef] [PubMed]
- Li, Y.; Yan, Y.; Deng, S.; Zhang, C.; Haq, F.; Chen, T.; Li, Y.; Li, S.; Yang, R.; Zou, L. The Xanthomonas oryzae pv. oryzae type IV pilus alignment subcomplex protein PilN contributes to regulation of bacterial surface-associated behaviours and T3SS system. Plant Pathol. 2020, 69, 744–755. [Google Scholar] [CrossRef]
- Wu, Z.; Zhang, Y.; Xu, X.; Ahmed, T.; Yang, Y.; Loh, B.; Leptihn, S.; Yan, C.; Chen, J.; Li, B. The holin-endolysin lysis system of the OP2-Like phage X2 infecting Xanthomonas oryzae pv. oryzae. Viruses 2021, 13, 1949. [Google Scholar] [CrossRef] [PubMed]
- Vu, N.T.; Oh, C.-S. Bacteriophage usage for bacterial disease management and diagnosis in plants. Plant. Pathol. J. 2020, 36, 204. [Google Scholar] [CrossRef] [PubMed]
- Álvarez, B.; López, M.M.; Biosca, E.G. Biocontrol of the major plant pathogen Ralstonia solanacearum in irrigation water and host plants by novel waterborne lytic bacteriophages. Front. Microbiol. 2019, 10, 2813. [Google Scholar] [CrossRef] [PubMed]
- Wang, X.; Wei, Z.; Yang, K.; Wang, J.; Jousset, A.; Xu, Y.; Shen, Q.; Friman, V.-P. Phage combination therapies for bacterial wilt disease in tomato. Nat. Biotechnol. 2019, 37, 1513–1520. [Google Scholar] [CrossRef]
- Fernández, L.; Gutiérrez, D.; Rodríguez, A.; García, P. Application of bacteriophages in the agro-food sector: A long way toward approval. Front. Cell. Infect. Microbiol. 2018, 8, 296. [Google Scholar] [CrossRef]
- Sulakvelidze, A. Using lytic bacteriophages to eliminate or significantly reduce contamination of food by foodborne bacterial pathogens. J. Sci. Food Agric. 2013, 93, 3137–3146. [Google Scholar] [CrossRef] [PubMed]
- Svircev, A.; Roach, D.; Castle, A. Framing the Future with Bacteriophages in Agriculture. Viruses 2018, 10, 218. [Google Scholar] [CrossRef]
- Clokie, M.R.; Millard, A.D.; Letarov, A.V.; Heaphy, S. Phages in nature. Bacteriophage 2011, 1, 31–45. [Google Scholar] [CrossRef] [PubMed]
- Zhang, M.; Wang, Y.; Chen, J.; Hong, X.; Xu, X.; Wu, Z.; Ahmed, T.; Loh, B.; Leptihn, S.; Hassan, S. Identification and Characterization of a New Type of Holin-Endolysin Lysis Cassette in Acidovorax oryzae Phage AP1. Viruses 2022, 14, 167. [Google Scholar] [CrossRef]
- Labrie, S.J.; Samson, J.E.; Moineau, S. Bacteriophage resistance mechanisms. Nat. Rev. Microbiol. 2010, 8, 317–327. [Google Scholar] [CrossRef] [PubMed]
- Sommer, J.; Trautner, C.; Witte, A.K.; Fister, S.; Schoder, D.; Rossmanith, P.; Mester, P.-J. Don’t shut the stable door after the phage has bolted—The importance of bacteriophage inactivation in food environments. Viruses 2019, 11, 468. [Google Scholar] [CrossRef] [PubMed]
- Heller, K.; Ölschläger, T.; Schwarz, H. Infection of LPS mutants of Escherichia coli B by phage T6. FEMS Microbiol. Lett. 1983, 17, 1–6. [Google Scholar] [CrossRef][Green Version]
- Perry, L.L.; SanMiguel, P.; Minocha, U.; Terekhov, A.I.; Shroyer, M.L.; Farris, L.A.; Bright, N.; Reuhs, B.L.; Applegate, B.M. Sequence analysis of Escherichia coli O157: H7 bacteriophage ΦV10 and identification of a phage-encoded immunity protein that modifies the O157 antigen. FEMS Microbiol. Lett. 2009, 292, 182–186. [Google Scholar] [CrossRef] [PubMed]
- Farooq, T.; Hussain, M.D.; Shakeel, M.T.; Tariqjaveed, M.; Aslam, M.N.; Naqvi, S.A.H.; Amjad, R.; Tang, Y.; She, X.; He, Z. Deploying viruses against phytobacteria: Potential use of phage cocktails as a multifaceted approach to combat resistant bacterial plant pathogens. Viruses 2022, 14, 171. [Google Scholar] [CrossRef]
- Ogunyemi, S.O.; Chen, J.; Zhang, M.; Wang, L.; Masum, M.; Islam, M.; Yan, C.; An, Q.; Li, B.; Chen, J. Identification and characterization of five new OP2-related Myoviridae bacteriophages infecting different strains of Xanthomonas oryzae pv. oryzae. J. Plant Pathol. 2019, 101, 263–273. [Google Scholar] [CrossRef]
- Buttimer, C.; McAuliffe, O.; Ross, R.P.; Hill, C.; O’Mahony, J.; Coffey, A. Bacteriophages and bacterial plant diseases. Front. Microbiol. 2017, 8, 34. [Google Scholar] [CrossRef]
- Alseth, E.O.; Pursey, E.; Luján, A.M.; McLeod, I.; Rollie, C.; Westra, E.R. Bacterial biodiversity drives the evolution of CRISPR-based phage resistance. Nature 2019, 574, 549–552. [Google Scholar] [CrossRef]
- Doffkay, Z.; Dömötör, D.; Kovács, T.; Rákhely, G. Bacteriophage therapy against plant, animal and human pathogens. Acta Biologica Szegediensis 2015, 59, 291–302. [Google Scholar]
- Penfold, R.J.; Pemberton, J.M. An improved suicide vector for construction of chromosomal insertion mutations in bacteria. Gene 1992, 118, 145–146. [Google Scholar] [CrossRef]
- Gao, G.; Lu, H.; Huang, L.; Hua, Y. Construction of DNA damage response genepprI function-deficient and function-complementary mutants inDeinococcus radiodurans. Chin. Sci. Bull. 2005, 50, 311–316. [Google Scholar] [CrossRef]
- Liu, H.; Tian, W.-X.; Ibrahim, M.; Li, B.; Zhang, G.-Q.; Zhu, B.; Xie, G.-L. Characterization of pilP, a gene required for twitching motility, pathogenicity, and biofilm formation of Acidovorax avenae subsp. avenae RS-1. Eur. J. Plant Pathol. 2012, 134, 551–560. [Google Scholar] [CrossRef]
- Zhang, M.; Qian, J.; Xu, X.; Ahmed, T.; Yang, Y.; Yan, C.; Elsharkawy, M.M.; Hassan, M.M.; Alorabi, J.A.; Chen, J. Resistance of Xanthomonas oryzae pv. oryzae to Lytic Phage X2 by Spontaneous Mutation of Lipopolysaccharide Synthesis-Related Glycosyltransferase. Viruses 2022, 14, 1088. [Google Scholar] [CrossRef]
- Ahmed, T.; Noman, M.; Shahid, M.; Shahid, M.S.; Li, B. Antibacterial potential of green magnesium oxide nanoparticles against rice pathogen Acidovorax oryzae. Mater. Lett. 2021, 282, 128839. [Google Scholar] [CrossRef]
- Ahmed, T.; Wu, Z.; Jiang, H.; Luo, J.; Noman, M.; Shahid, M.; Manzoor, I.; Allemailem, K.S.; Alrumaihi, F.; Li, B. Bioinspired green synthesis of zinc oxide nanoparticles from a native Bacillus cereus strain RNT6: Characterization and antibacterial activity against rice panicle blight pathogens Burkholderia glumae and B. gladioli. Nanomaterials 2021, 11, 884. [Google Scholar] [CrossRef]
- Evans, T.; Ind, A.; Komitopoulou, E.; Salmond, G. Phage-selected lipopolysaccharide mutants of Pectobacterium atrosepticum exhibit different impacts on virulence. J. Appl. Microbiol. 2010, 109, 505–514. [Google Scholar] [CrossRef]
- Holtappels, D.; Kerremans, A.; Busschots, Y.; Van Vaerenbergh, J.; Maes, M.; Lavigne, R.; Wagemans, J. Preparing for the KIL: Receptor analysis of Pseudomonas syringae pv. porri phages and their impact on bacterial virulence. Int. J. Mol. Sci. 2020, 21, 2930. [Google Scholar] [CrossRef]
- Clifton, I.J.; Ge, W.; Adlington, R.M.; Baldwin, J.E.; Rutledge, P.J. The crystal structure of isopenicillin N synthase with δ-(l-α-aminoadipoyl)-l-cysteinyl-d-methionine reveals thioether coordination to iron. Arch. Biochem. Biophys. 2011, 516, 103–107. [Google Scholar] [CrossRef] [PubMed]
- Cho, D.-Y.; Ko, H.M.; Kim, J.; Kim, B.-W.; Yun, Y.-S.; Park, J.-I.; Ganesan, P.; Lee, J.-T.; Choi, D.-K. Scoparone inhibits LPS-simulated inflammatory response by suppressing IRF3 and ERK in BV-2 microglial cells. Molecules 2016, 21, 1718. [Google Scholar] [CrossRef]
- Charnock, S.J.; Davies, G.J. Structure of the nucleotide-diphospho-sugar transferase, SpsA from Bacillus subtilis, in native and nucleotide-complexed forms. Biochemistry 1999, 38, 6380–6385. [Google Scholar] [CrossRef]
- Eugster, M.R.; Morax, L.S.; Hüls, V.J.; Huwiler, S.G.; Leclercq, A.; Lecuit, M.; Loessner, M.J. Bacteriophage predation promotes serovar diversification in Listeria monocytogenes. Mol. Microbiol. 2015, 97, 33–46. [Google Scholar] [CrossRef] [PubMed]
- Petrocelli, S.; Tondo, M.L.; Daurelio, L.D.; Orellano, E.G. Modifications of Xanthomonas axonopodis pv. citri lipopolysaccharide affect the basal response and the virulence process during citrus canker. PLoS ONE 2012, 7, e40051. [Google Scholar] [CrossRef]
- Pérez-Pascual, D.; Gómez, E.; Guijarro, J.A. Lack of a type-2 glycosyltransferase in the fish pathogen Flavobacterium psychrophilum determines pleiotropic changes and loss of virulence. Vet. Res. 2015, 46, 1–9. [Google Scholar] [CrossRef] [PubMed]
- Magar, R.T.; Lee, S.Y.; Kim, H.J.; Lee, S.W. Biocontrol of bacterial wilt in tomato with a cocktail of lytic bacteriophages. Appl. Microbiol. Biotechnol. 2022, 106, 3837–3848. [Google Scholar] [CrossRef] [PubMed]
- Kering, K.K.; Kibii, B.J.; Wei, H. Biocontrol of phytobacteria with bacteriophage cocktails. Pest Manag. Sci. 2019, 75, 1775–1781. [Google Scholar] [CrossRef]
- Jones, J.B.; Jackson, L.E.; Balogh, B.; Obradovic, A.; Iriarte, F.B.; Momol, M.T. Bacteriophages for plant disease control. Ann. Rev. Phytopathol. 2007, 45, 245–262. [Google Scholar] [CrossRef] [PubMed]
- Dy, R.L.; Richter, C.; Salmond, G.P.; Fineran, P.C. Remarkable mechanisms in microbes to resist phage infections. Annu. Rev. Virol. 2014, 1, 307–331. [Google Scholar] [CrossRef]
- Harvey, H.; Bondy-Denomy, J.; Marquis, H.; Sztanko, K.M.; Davidson, A.R.; Burrows, L.L. Pseudomonas aeruginosa defends against phages through type IV pilus glycosylation. Nat. Microbiol. 2018, 3, 47–52. [Google Scholar] [CrossRef]
- Wang, X.Q.; Loh, B.; Altamirano, F.G.; Yu, Y.S.; Hua, X.T.; Leptihn, S. Colistin-phage combinations decrease antibiotic resistance in Acinetobacter baumannii via changes in envelope architecture. Emerg. Microbes Infect. 2021, 10, 2205–2219. [Google Scholar] [CrossRef] [PubMed]
- Liu, N.; Lewis, C.; Zheng, W.M.; Fu, Z.Q. Phage Cocktail Therapy: Multiple Ways to Suppress Pathogenicity. Trends Plant Sci. 2020, 25, 315–317. [Google Scholar] [CrossRef] [PubMed]

| Mutants | CDS no. (%Sequence Similarity) | Functional Prediction of Genes | ||
|---|---|---|---|---|
| Name | Length | Description | ||
| Tn5-(1, 66, 214, 673, 743, 1411, 2049) | C2_813 (98.31–100) | rmlA | 888 | glucose-1-phosphate thymidylyltransferase |
| Tn5-(2/383) | C2_795 (98.48, 100) | metB | 1194 | cystathionine gamma-synthase |
| Tn5-8 | C2_601 (98.63) | tagB | 1056 | putative glycosyl/glycerophosphate transferases |
| Tn5-10 | C2_811 (100) | etfB | 747 | electron transfer flavoprotein beta subunit |
| Tn5-(20, 677, 684, 769, 837) | C2_801 (98.94–100) | ― | 711 | glycosyl transferase |
| Tn5-(39, 55) | C2_812 (98.83/100) | rmlB | 975 | dTDP-glucose 4, 6-dehydratase |
| Tn5-231 | C2_918 (99.54) | ― | 99 | Transposase |
| Tn5-238 | C2_794 (99.88) | cysB | 1377 | cystathionine beta-synthase |
| Tn5-239 | C2_797 (99.56) | ― | 801 | Hypothetical protein |
| Tn5-283 | C2_804 (99.65) | wxoD | 336 | putative O-antigen acetylase |
| Tn5-488 | C2_1771 (100) | ― | 2100 | glycosyl transferase |
| Tn5-(722, 685, 873, 1116) | C2_803 (99.85–100) | ― | 243 | Hypothetical protein |
| Tn5-(741, 2047) | C2_798 (98.66, 99.95) | ― | 462 | NAD dependent dehydrase |
| Tn5-1070 | C2_2234 (98.83) | rfb303 | 969 | lipopolysaccharide core biosynthesis protein |
| Tn5-1157 | C2_68 (100) | ― | 681 | Predicted nucleoside-diphosphate-sugar epimerases |
| Tn5-1423 | C2_3900 (98.66) | lpxH | 743 | UDP-2,3- diacylglucosamine diphosphatase |
| Tn5-1538 | C2_3261 (100) | ― | 2328 | The twin-arginine translocation (Tat) pathway signal protein |
| Tn5-1937 | C2_802 (99.65) | ― | 291 | Hypothetical protein |
| Tn5-(2040, 2286) | C2_820 (99.71/99.89) | ― | 2088 | Hypothetical protein |
| Strains | Relevant Characteristics | References |
|---|---|---|
| X. oryzae pv oryzae strains | ||
| C2 | wild type, the pathogen of rice bacterial blight | In our lab |
| C2_803 | KmR; C2 insertional mutant defective in C2_803 | This study |
| C2_1771 | KmR; C2 insertional mutant defective in C2_1771 | This study |
| C2_2234 | KmR; C2 insertional mutant defective in C2_2234 | This study |
| C2_803-comp | ChlR, KmR; complement strain of C2_803 | This study |
| C2_1771-comp | ChlR, KmR; complement strain of C2_1771 | This study |
| C2_2234-comp | ChlR, KmR; complement strain of C2_2234 | This study |
| phage X2 Xoo | Isolated from pathogen of rice bacterial blight | In our lab |
| E. coli strains | ||
| DH5α | Recombinant plasmid replication | Qingke Hangzhou |
| S17-1 λpir | Recombinant plasmid replication | Simon et al. (1983) |
| pJP5603 plasmid and its derivatives | ||
| pJP5603 | Suicide plasmid, KmR | Penfold et al. (1992) |
| pJP5603-803 | KmR, pJP5603 with C2_803 flanking fragment | This study |
| pJP5603-1771 | KmR, pJP5603 with C2_1771 flanking fragment | This study |
| pJP5603-2234 | KmR, pJP5603 with C2_2234 flanking fragment | This study |
| Plasmids vector pRADK and its derivatives | ||
| pRADK | AmpR, ChlR, KanR, the broad-spectrum host expression vector | Gao et al. (2005) |
| pRADK-803 | AmpR, ChlR, KanR, pRADK with C2_803 flanking fragment | This study |
| pRADK-1771 | AmpR, ChlR, KanR, pRADK with C2_1771 flanking fragment | This study |
| pRADK-2234 | AmpR, ChlR, KanR, pRADK with C2_2234 flanking fragment | This study |
| Primers | Primer Sequences (5′-3′) | Targeted Genes | |
|---|---|---|---|
| Name | Length (bp) | ||
| Kan-F | AAGGTAGCGTTGCCAATGAT | KanR | 567 |
| Kan-R | GCCGTTTCTGTAATGAAGGA | ||
| KAN-2 FP-1 | ACCTACAACAAAGCTCTCATCAACC | KanR | 162 |
| KAN-2 RP-1 | GCAATGTAACATCAGAGATTTTGAG | ||
| 803-F | CGGGATCCGCGTGGCTATTGCGAGGAG | C2_803 | 217 |
| 803-R | CGGAATTCGTGCACAAACGCTTCTACCTG | ||
| 1771-F | CGGGATCCGCGTCCTGATACAGACGCAC | C2_1771 | 1538 |
| 1771-R | CGGAATTCGTGCTGCTCAACAACGACAC | ||
| 2234-F | CGGGATCCGTGCGTGCTGCACCTGCTG | rfb303 | 968 |
| 2234-R | CGGAATTCCAGGAATTGCGCAGTCCATCG | ||
| 803-C-F | GAGCTCGAATTCTAGACGGTGTATAACGGGCGGG | C2_803 | 604 |
| 803-C-R | GCAGAAGCTTCTAGAGTGCACAAACGCTTCTACCTG | ||
| 1771-C-F | GAGCTCGAATTCTAGACTTGCACAACGCTGGGTTG | C2_1771 | 2602 |
| 1771-C-R | GCAGAAGCTTCTAGACCAACGCAATGTCGATGTC | ||
| 2234-C-F | GAGCTCGAATTCTAGAGGAAGGGCGCATCGAAGC | rfb303 | 1475 |
| 2234-C-R | GCAGAAGCTTCTAGACAGGAATTGCGCAGTCCATCG | ||
Publisher’s Note: MDPI stays neutral with regard to jurisdictional claims in published maps and institutional affiliations. |
© 2022 by the authors. Licensee MDPI, Basel, Switzerland. This article is an open access article distributed under the terms and conditions of the Creative Commons Attribution (CC BY) license (https://creativecommons.org/licenses/by/4.0/).
Share and Cite
Liu, M.; Tian, Y.; Zaki, H.E.M.; Ahmed, T.; Yao, R.; Yan, C.; Leptihn, S.; Loh, B.; Shahid, M.S.; Wang, F.; et al. Phage Resistance Reduced the Pathogenicity of Xanthomonas oryzae pv. oryzae on Rice. Viruses 2022, 14, 1770. https://doi.org/10.3390/v14081770
Liu M, Tian Y, Zaki HEM, Ahmed T, Yao R, Yan C, Leptihn S, Loh B, Shahid MS, Wang F, et al. Phage Resistance Reduced the Pathogenicity of Xanthomonas oryzae pv. oryzae on Rice. Viruses. 2022; 14(8):1770. https://doi.org/10.3390/v14081770
Chicago/Turabian StyleLiu, Mengju, Ye Tian, Haitham E. M. Zaki, Temoor Ahmed, Rong Yao, Chengqi Yan, Sebastian Leptihn, Belinda Loh, Muhammad Shafiq Shahid, Fang Wang, and et al. 2022. "Phage Resistance Reduced the Pathogenicity of Xanthomonas oryzae pv. oryzae on Rice" Viruses 14, no. 8: 1770. https://doi.org/10.3390/v14081770
APA StyleLiu, M., Tian, Y., Zaki, H. E. M., Ahmed, T., Yao, R., Yan, C., Leptihn, S., Loh, B., Shahid, M. S., Wang, F., Chen, J., & Li, B. (2022). Phage Resistance Reduced the Pathogenicity of Xanthomonas oryzae pv. oryzae on Rice. Viruses, 14(8), 1770. https://doi.org/10.3390/v14081770

